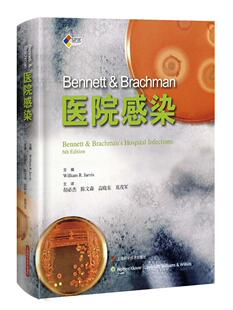

真正 Real 扭曲 真相 Agenda Warning Extraterrestrial 外星议程 海外直订Bent 警告 Truth
¥123满99减5售0件

Sorensen 氢与燃料电池——新兴 Bent 原书第2版 国际电气工程先进技术译丛 技术及其应用
¥76.56满30减3售0件

摸索开始:奎因 狗 the One Bent with Quinn Dog 一只耳朵弯曲 海外直订Fumble Ear Beginnings
¥135满99减5售0件

Noses 海外直订Burnt Bent and 烤面包和弯鼻子 Toast
¥135满99减5售0件

Success 一心要成功 Bent 海外直订Hell
¥135满99减5售0件

9781417927166 Twig Bent 按需印刷The
¥274满200减10售0件

9781120266590 按需印刷The 1915 Twig Bent
¥274满200减10售0件

Success 一心求成功 Bent 海外直订Hell
¥140满99减5售0件

Job The 预订Bent For
¥171满100减6售0件

本特辐条案:白杨湾之谜 Mystery Cove Poplar Spoke Bent the Case 海外直订The
¥144满99减5售0件

BUT BENT NOT BROKEN 预售 9781496743183 2025新书
¥185满100减6售0件

Performance Grounds Suzuki Butoh 1982 Strange Australia 2023 Legs and 4周达 9789004712300 Bent
¥1555满500减50售0件

尺寸 你 海外直订Bent Dimensions
¥161满99减5售0件

氢与燃料电池——新兴 Sorensen 技术及其应用 Bent 隋升 原书第2版 机工
¥98满85减3售0件

Buffalo 用弯曲 With Nails 钉子捕猎水牛 Bent 海外直订Hunting
¥166满99减5售0件

Buffalo 用弯曲 with Nails 钉子捕猎水牛 Bent 海外直订Hunting
¥177满99减5售0件

Dodgy and Wickets 弯曲 小门 海外直订Bent 手臂和狡猾 Arms
¥182.4满99减5售0件

Smile 出生时俯身:中年时垂直微笑 Over Age Middle Vertical the Flashing Bent 海外直订Born
¥185满99减5售0件

Stories 生境:弯曲现实主义 Realism 故事 Bent 海外直订Habitat
¥188满99减5售0件

Philosophy 9781138173316 Tongue Bent 4周达 Genius Ordinary and our Language The
¥1998满500减50售0件

Bent Giuseppe 技术及其应用 朱塞佩·斯帕扎富莫 意 S?rensen 本特·索伦森 丹 原书第3版 氢与燃料电池——新兴 机工
¥122.9满85减3售0件

9780898592719 Programs Lasting 4周达 Effects Twig the Preschool Bent
¥2057满500减50售0件

Bent Functions Fundamentals Results 4周达 and 9783319813226
¥2598满500减50售0件

Bent Functions Fundamentals Results 4周达 and 9783319325934
¥2598满500减50售0件

Flyvbjerg编著 Bent 9787576508666 丹 牛津重大项目管理指南
¥176.5满79减3售0件

Physical 9781482247596 Bent Crystals Structures Liquid 4周达 Shaped Properties and
¥3027满500减50售0件

9787576508666 丹 Bent 同济大学出版 牛津重大项目管理指南 Flyvbjerg编著 社 官方正版
¥192.1满79减3售0件
医院感染控制医药卫生书籍 Brachman医院感染 Bent
¥46.646.6售0件

Brachman医院感染 上海科学技术出版 社 9787547830475 书籍正版 医药卫生 Bent
¥64.764.7售0件

书籍 社医药卫生医院感染控制 Bent Brachman医院感染上海科学技术出版 人天书店畅销书排行榜 正版
¥46.746.7售0件